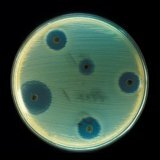
Все что нужно знать про лечение антибиотиками

Все что нужно знать про лечение антибиотиками
На данный момент, при развитии медицины, очень часто приходится сталкиваться с лечением инфекционных заболеваний. В своем преимущественном большинстве данные заболевания вызваны микробной флорой. Основным методом борьбы с данными заболеваниями является назначение врачами антибиотиков. В данной статье мы рассмотрим все что нужно знать про лечение антибиотиками.
На данный момент, при развитии медицины, очень часто приходится сталкиваться с лечением инфекционных заболеваний. В своем преимущественном большинстве данные заболевания вызваны микробной флорой. Основным методом борьбы с данными заболеваниями является назначение врачами антибиотиков. В данной статье мы рассмотрим все что нужно знать про лечение антибиотиками.
Изобретение антибиотиков вывело медицину на новый уровень, и позволило бороться с болезнями, излечение от которых в прошлом было практически невозможным. Первыми препаратами данной группы являются: пенициллин и стрептомицин.
Огромное количество заболеваний вызвано именно патогенными микроорганизмами. Адекватными мерами является назначение врачом того или иного антибактериального препарата, что повлечет за собой позитивные действия, так как микробы под воздействием лекарства погибнут.
Нужно отметить, что назначение любого антибиотика это плохо для нашего организма. Любой антибиотик несет в себе негативные действие для органов и систем тела человека, но при осознании этого факта, нужно четко взвешивать и опасность влияния инфекции микробного характера на наш организм. Лечение антибиотиками не только улучшает прогнозы на выздоровление, но и зачастую просто жизненно необходимо для сохранения здоровья.
В повседневной жизни важно знать про данные антибиотики:
Бетта-лактамные, к ним относятся: пенициллины, в основном довольно слабые препараты, но тем не менее, у них мало побочных эффектов, и если микробная флора хорошо поддается лечению, то почему бы их и не назначить. цефалоспорины, сходны с пред ведущей группой, но обладают более сильным действием. Надо отметить, что при небольшом риске побочных реакций, есть значительная вероятность возникновения аллергических реакций различного типа.
Макролиды - обладают сложной циклической структурой, по своему воздействию, не убивают микробы, но выполняют не менее важную функцию, останавливают размножение микробной флоры внутри организма.
Тетрациклины - их применение направленно на борьбу с серьезными инфекциями, действие данных препаратов также направленно на остановку размножения и развития микробов.
Аминогликозиды - также используются при тяжелых инфекциях, но в отличии от предыдущей группы убивают микроорганизмы. Очень ядовиты, плохо влияют на организм человека.
Левомицетины - так называемые препараты резерва, действие останавливает размножение бактерий, но являются чрезмерно токсичными.
Гликопептидные антибиотики - их действие состоит в том что они нарушают оболочку микробной клетки, тем самым приводя к ее гибели. Достаточно сильные препараты.
Противотуберкулёзные препараты – из названия ясно, что данная группа лекарств направлена на лечение туберкулеза.
Карбапенемы - Все что нужно знать про карбапенемы, это то, что достаточно сильные антибиотики, но помогаю очень выборочно.
Чем же оперируют врачи при лечении антибиотиками?
Все что нужно знать для правильного назначения препарата это устойчивость микроорганизма к антибиотику. Если устойчивости, к какому либо виду препарата нет, выбор падает именно на него. Для проверки устойчивости лаборатории используют нанесение различных антибактериальных средств на культуру микроорганизмов, которую специально выращивают из взятого в больнице посева.
Существуют также определение вида микроорганизма на аэробные и анаэробные, грам. позитивные и грам. негативные. Под каждый из этих видов, есть определенные препараты, различной силы действия, а также с различными побочными эффектами.
Но определение всех вышеперечисленных факторов, зачастую либо очень замедленно, либо невозможно по ряду различных причин: уровень и оснащение лаборатории, ценовая политика, и т.д. и т.п.
Поэтому очень часто все, что нужно знать врачу при лечении антибиотиками это своеобразные признаки, которые проявляют различные бактерии, по этим признакам, а так же по простейшим анализам, которые врач может провести самостоятельно, антибиотики назначаются эмпирически.
Принципы эмпирического назначения антибиотиков
При лечении антибиотиками неизвестных микроорганизмов применяются метод либо эскалационной терапии, что означает, назначение препарата от более слабого, к более сильному, пока какой-то из них не начнет работать, либо второй метод деэскалационной терапии, когда назначают самый сильный антибиотик, а затем переходят на более слабые лекарства.
Взаимодействие антибиотиков с алкоголем
Антибиотики с алкоголем применять нельзя и точка. Взаимодействие данных химических веществ между собой в теле человека могут привести к серьезным нарушениям обмена веществ. Данный факт грозит риском серьезных осложнений, которые могут проявиться такими неприятными последствиями как: печеночная недостаточность, сильная интоксикация организма, пагубное воздействие на нервную систему. Очень часты случаи судорог, обмороков, шоков. Кроме того даже если алкоголь и антибиотики не вызовут данных осложнений, эффективность препаратов резко снизится, и получится так, что человек применял лечение антибиотиками в пустую.
Нельзя сторонится поддерживающей терапии при лечении антибиотиками
Все что нужно знать про поддерживающую терапию, это то, что применение пробиотиков, препаратов, которые восстанавливают нормальную микрофлору в кишечнике человека, очень важно. Применение такого вида лечения профилактирует проблемы с вашим кишечником в будущем.
Заключение
Напоследок хотелось бы сказать, что лечение антибиотиками играет огромную роль в медицине, и каждый человек, который сталкивается с подобными препаратами, должен знать принципы проводимой терапии. Иногда все что нужно, это один препарат, иногда, антибиотик приходится менять. В успешной борьбе с микробными инфекционными заболеваниями вам помогут врачи, и ваши собственные знания.